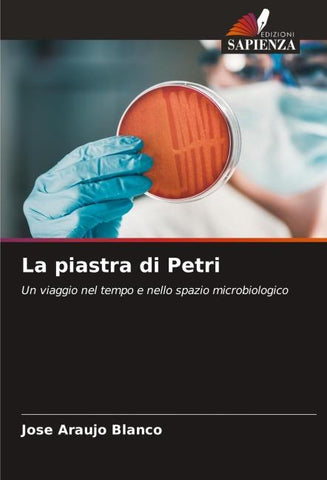
La piastra di Petri

Autorenfreundlich Bücher kaufen?!

Beschreibung
Un viaggio nel tempo e nello spazio microbiologico
Details
| Verlag | Edizioni Sapienza |
| Ersterscheinung | 12. August 2024 |
| Maße | 22 cm x 15 cm x 0.8 cm |
| Gewicht | 197 Gramm |
| Format | Softcover |
| ISBN-13 | 9786207929108 |
